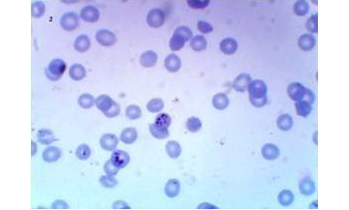
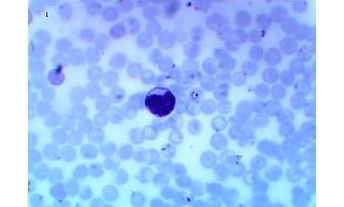

The Journal of Advances in Parasitology
Ring stage of P. falciparum in a thin blood smear using oil immersion lens
Gametocytes of P. falciparum in a thick blood smear using oil immersion lens.
Ring stage of P. vivax in a thin blood smear using oil immersion lens
Agarose gel electrophoresis of 1st run nested PCR product using Plasmodium genus-specific primers.
M: 100 bp ladder; PCR amplification product of 1100 bp was seen in all samples (lane 2-7); Lane 1: negative case control; Lane 8: positive case control; Lane 9: no template control
Agarose gel electrophoresis of nested PCR product using specific primer for P. vivax and P. falciparum
M: 50 bp ladder; The representative P. vivax were negative by using P. vivax specific primers lanes 1-4 (right panel) and the representative P. falciparum were positive at 205bp by using P. falciparum specific primers lanes 5-7 (left panel); Lane 8: negative case control; Lane 9: positive case control; Lane 10: no template control